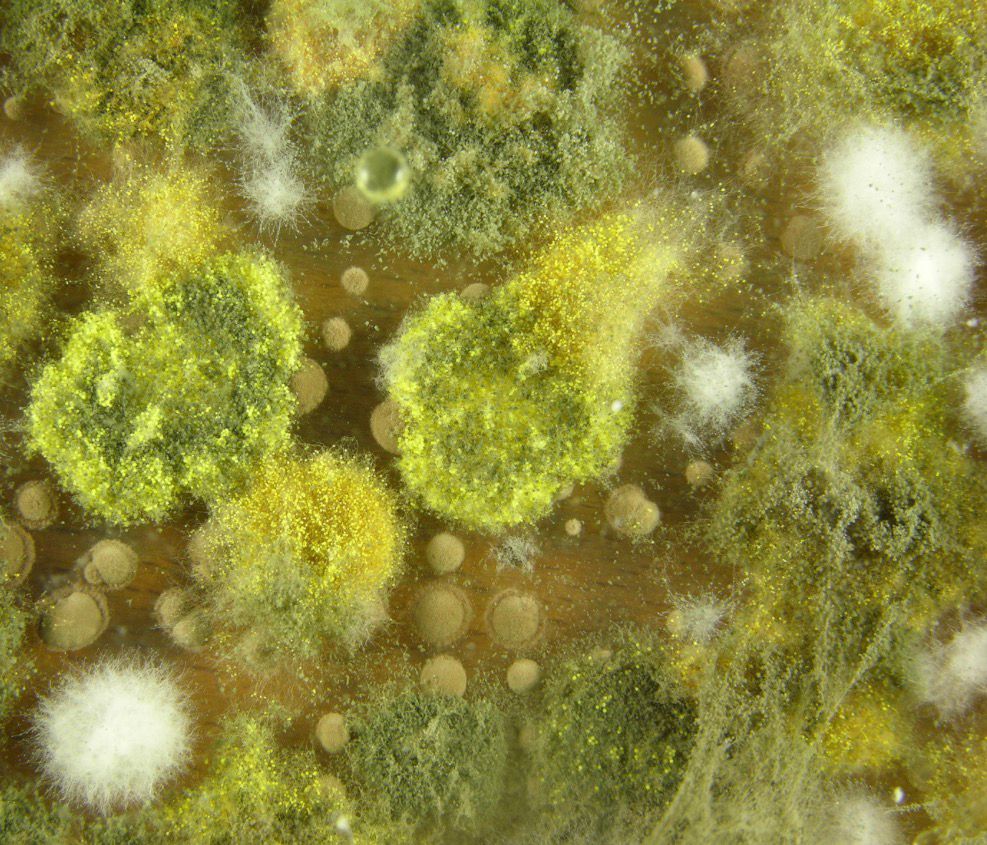
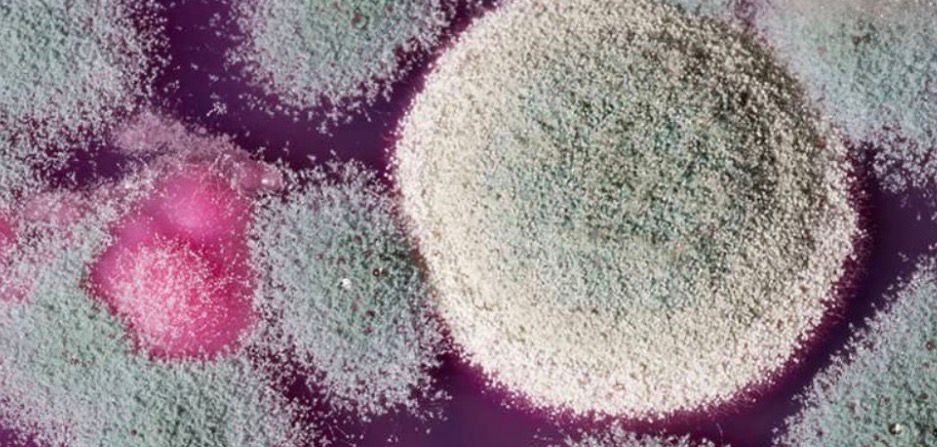

Joasia Rubinroth

Przyp. od adminki: Zdjęcia autorka lub skrin z internetu; błagamy autorów zdjęć, aby nam darowali, ale to jednak pleśń, w Niemczech straszny temat, używamy skrinów Waszych zdjęć do ostrzegania tubylców, przed śmiertelnym niebezpieczeństwem 🙂
